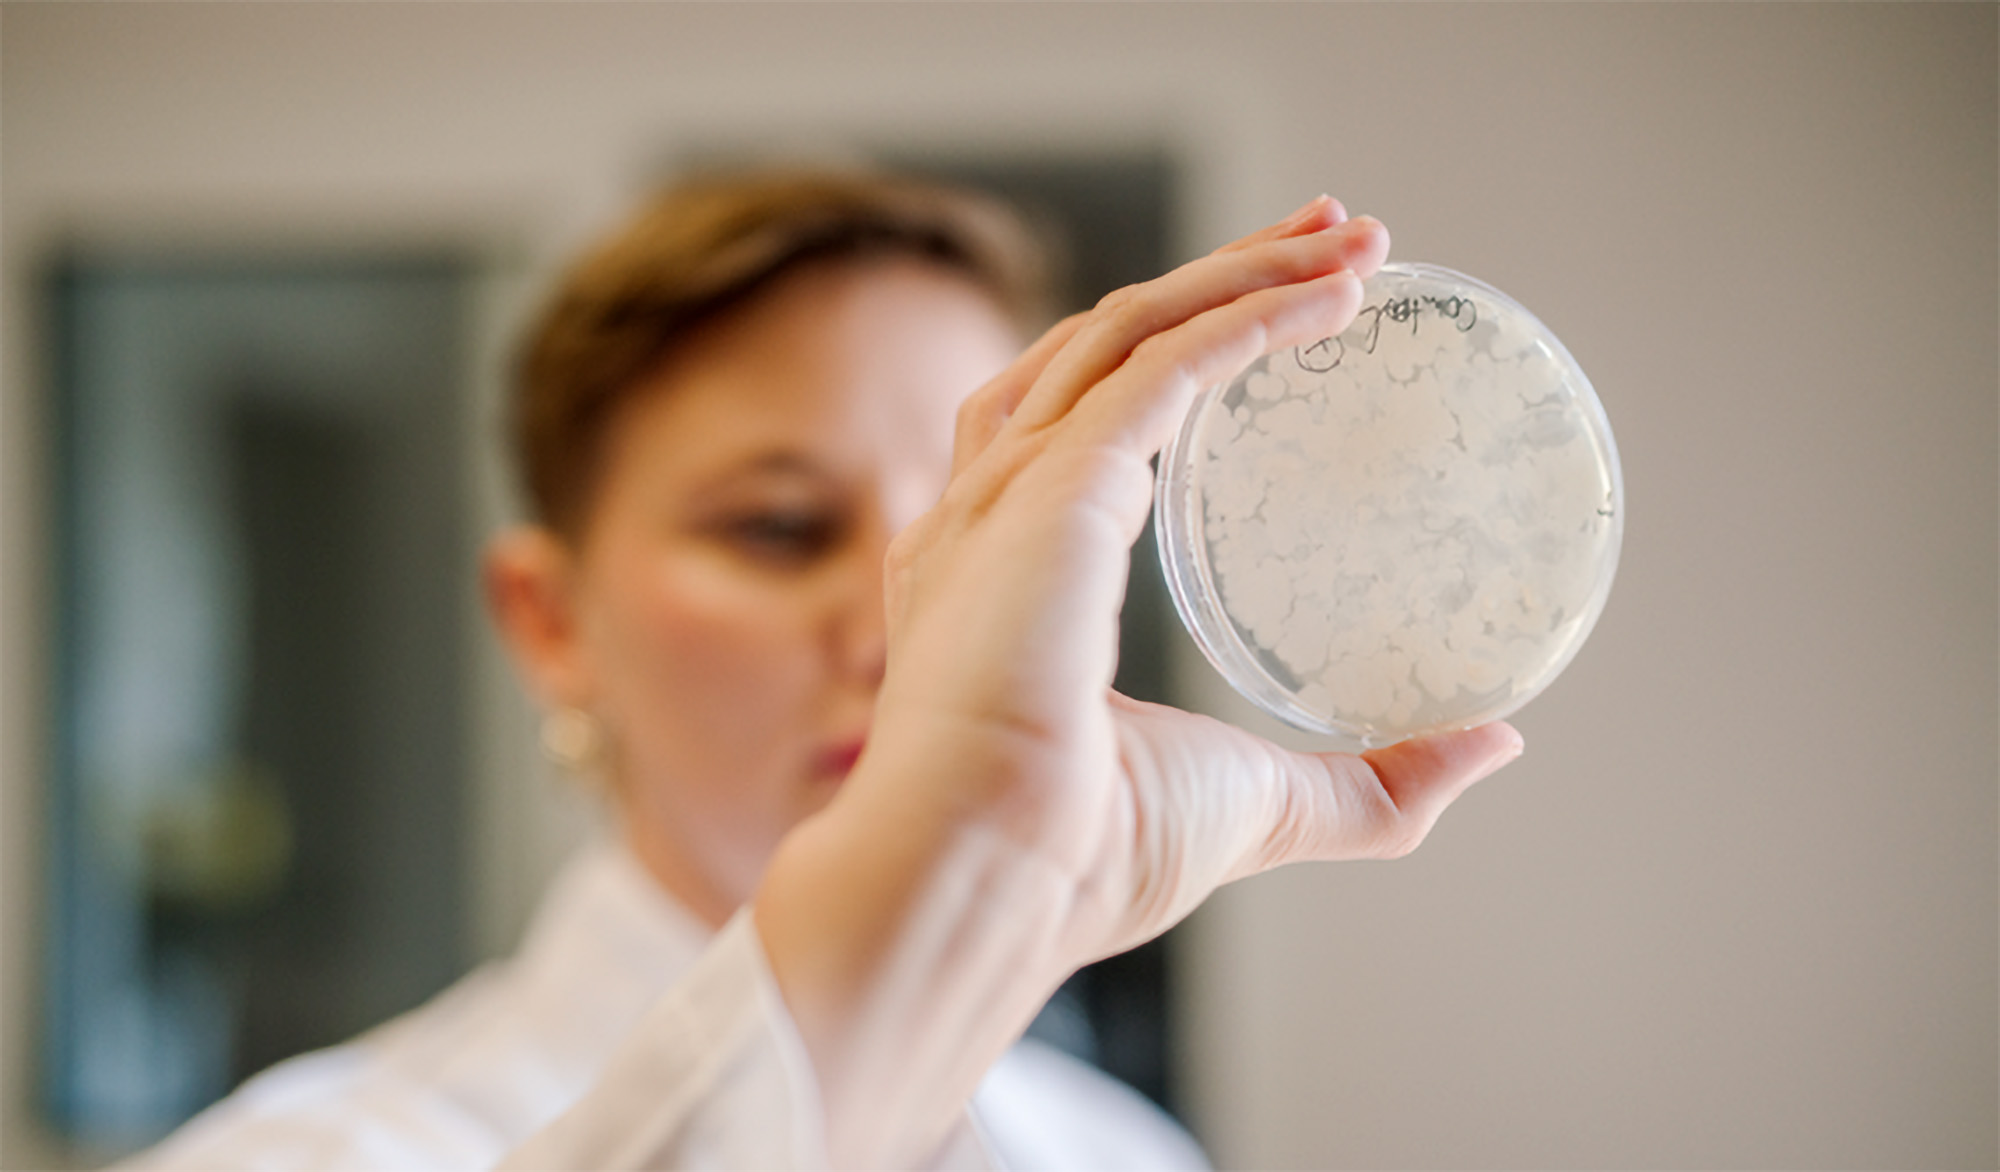

Green Spot Technologies raises €5 million to scale production and launch Milatea brand for sustainable bakery and confectionery ingredients
Green Spot Technologies has announced the completion of a €5 million funding round to accelerate industrial development and launch its new fermented-ingredient brand Milatea, aimed at the bakery, pastry, and confectionery markets.
The investment combines equity and bank financing, led by Team for the Planet (TFTP) alongside the EIC Accelerator, existing shareholders, and new business angels. The funds will enable Green Spot to expand its production capacity from 100 to 1,000 tons per year and strengthen its commercial presence across the food industry.
“We are proud to see our current investors renewing their trust and to welcome new partners who share our vision: fermenting the future of food,” commented Ninna Granucci, CEO & Co-founder of Green Spot Technologies. “This funding round will allow us to deploy our technology at scale and make our sustainable fermented ingredients accessible to more brands and consumers.”
Denis Galha Garcia, Co-founder of Team for the Planet, said: “This is our first investment in the agri-food sector. Concrete solutions exist to decarbonize this key industry. The next step is to scale them up.”
The new brand Milatea will provide semi-finished fermented ingredients, including powders, fillings, and inclusions designed for low-carbon, plant-based bakery and pastry applications. The line uses fava beans and plant fibers to deliver both functional and aromatic benefits while upcycling by-products from food manufacturing.
Milatea’s Ferment’Up range features a natural flavor palette spanning from cocoa-like notes to gingerbread tones, as well as fatty profiles reminiscent of olive oil and hazelnut. The company says the ingredients are designed to offer indulgent taste and texture while reducing environmental impact.
French ingredient distributor Firmalis described Milatea as a “sustainable solution without compromising indulgence” in a recent social media post highlighting the launch.
Green Spot currently operates a demonstration plant in Carpentras, southern France, capable of processing 100 tons of semi-finished ingredients annually. The new investment will support its expansion to 1,000 tons of production capacity within three years, enabling the company to upcycle 1,500 tons of plant by-products per year.

Founded in 2019, the Toulouse-based startup employs 24 people and has established itself as a European leader in fermentation technologies that convert food side streams into high-value ingredients.
The company’s growth strategy aligns with rising demand in France’s bakery, coffee shop, and sweet food sectors, which reached €19.9 billion in 2024, up 5.1% from 2023. Combined, these three markets represent around €5 billion, with bakery up 8.16%, coffee shops up 7.7%, and sweet foods up 13.49% year-on-year.
French bakery-pastry exports also increased by 25% between 2015 and 2019, with 80% going to other EU countries – evidence, Green Spot says, of the strong international appetite for high-quality, innovative French ingredients such as its fermented ranges.
Green Spot’s research partnerships span Europe and beyond, including collaborations with AgroParisTech, INRAE, the University of Copenhagen, and the University of Auckland in New Zealand. The company also works with renowned culinary and food science institutions such as Institut Lyfe (Paul Bocuse) and École d’ingénieurs Purpan in Toulouse.

The company is an active member of Bpifrance’s Coq Vert community, the Ferments du Futur consortium (led by INRAE and ANIA), and the AGIR Technical Center. It is also involved in large public R&D programs such as M2ProLIV (CIRAD) and DOMINO, a European collaborative project supporting sustainable protein innovation.
Green Spot has received multiple international distinctions for its technology and environmental impact. It was a finalist for The Earthshot Prize 2024, a winner of the EIC Accelerator, and has been recognized by FrenchTech Agri20 and FrenchTech 2030. The company also won the Kraft Heinz Innovation Challenge and was co-winner of the Bühler New Chocolate Challenge.
Green Spot’s technology enables the controlled fermentation of agricultural side streams into functional ingredients that enhance flavor, nutrition, and sustainability. The process reduces waste and supports circularity in food manufacturing.
“The versatility of our technology allows us not only to reduce food waste but also to co-create innovative, sustainable, and high-performance fermented solutions with our partners,” said Granucci.
The company plans to continue expanding its portfolio and co-developing tailor-made fermentation solutions with global food-industry partners. Through Milatea, Green Spot aims to demonstrate how fermentation can bridge culinary heritage with future-focused sustainability.
“We see enormous opportunity in combining indulgence, health, and environmental responsibility,” Granucci said. “Milatea is our next step toward making fermentation the standard for sustainable, delicious food.”
If you have any questions or would like to get in touch with us, please email info@futureofproteinproduction.com




